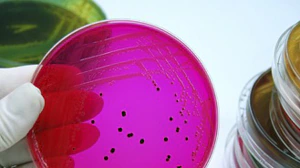
salmonella-300px.jpg Petri dish of Salmonella

Information for Healthcare Professionals and Laboratories
CDC has observed an increase in certain Salmonella infections among travelers to or from Mexico. The Salmonella causing these infections are a strain of multidrug-resistant Salmonella serotype Newport. See guidance for diagnosing and treating patients known or suspected to have an infection with this strain of Salmonella.
Salmonella & Antimicrobial Resistance

Healthcare professionals can view antimicrobial resistance data for Salmonella using antibiograms on Sanford Guide’s mobile app and website. The data come from CDC’s National Antimicrobial Resistance Monitoring System (NARMS) and are also available through NARMS Now, an interactive web tool containing data on selected enteric bacteria isolated from humans.
Estimates
CDC estimates that approximately 1.35 million illnesses and 420 deaths occur due to non-typhoidal Salmonella annually in the United States1.
Incidence
FoodNet reports that the annual incidence of Salmonella infection in the United States was 15.2 illnesses per 100,000 individuals2.
Trends
Compared to 2010-2012, the incidence of non-typhoidal Salmonella infection showed a 9% decrease in 20132. Visit the FoodNet website for more detailed information about the most recent trends in Salmonella infection.
Risk Factors
- Salmonella infection is more common in the summer months (June, July, and August) than winter.
- Children under 5 years old are the most likely to get a Salmonella infection3.
- Infants who are not breast fed are more likely to get a Salmonella infection4.
- Children who are 5 years old and younger, adults over 65 years old, and people with weakened immune systems are the most likely to have severe infections.
- Certain medications (for example, medications to reduce stomach acid) can increase the risk of Salmonella infection5.
Outbreaks
In 2012, 831 foodborne outbreaks were reported to CDC6. They were caused by a variety of pathogens, and 106 of them were confirmed Salmonella. Salmonella accounted for the most hospitalizations (64%) in outbreaks with a confirmed cause6. In the largest recent outbreak, between March 2013 and July 2014, over 600 individuals in 29 states and Puerto Rico were infected with seven outbreak strains of Salmonella Heidelberg7. This outbreak was associated with one brand of chicken, that led to a company recall of over 40,000 pounds of chicken products8, and ended after the company instituted new control measures to reduce contamination.
- CDC. Antibiotic Resistance Threats in the United States, 2019. Atlanta, GA: U.S. Department of Health and Human Services, CDC; 2019.
- CDC. Incidence and Trends of Infection with Pathogens Transmitted Commonly Through Food — Foodborne Diseases Active Surveillance Network, 10 U.S. Sites, 2006–2013. MMWR Morb Mortal Wkly Rep. 2014;63(15);328-332
- CDC. Foodborne Diseases Active Surveillance Network (FoodNet): FoodNet Surveillance Report for 2012 (Final Report) [PDF – 53 pages]. Atlanta, Georgia: U.S. Department of Health and Human Services, CDC. 2014.
- Jones TF, et al. A case-control study of the epidemiology of sporadic Salmonella infection in infants. Pediatrics. 2006; 118(6): 2380-2387.
- Bavishi C, DuPont HL. Systematic Review: The use of proton pump inhibitors and increased susceptibility to enteric infection. Alimentary Pharmacology & Therapeutics. 2011; 34(11-12): 1269-1281.
- CDC. Surveillance for Foodborne Disease Outbreaks, United States, 2012, Annual Report [PDF – 20 pages]. Atlanta, Georgia: US Department of Health and Human Services, CDC, 2014.
- CDC. Multistate Outbreak of Multidrug-Resistant Salmonella Heidelberg Infections Linked to Foster Farms Brand Chicken. 2014.
- FSIS. California Wholesale Store Recalls Rotisserie Chicken Products Due to Possible Salmonella Heidelberg Contamination. 2013.
- American Public Health Association. Control of Communicable Diseases Manual 19th edition, An Official Report of the American Public Health Association. 19th edition. 2008.
- CDC, National Salmonella Surveillance Data, unpublished, 2013
- Centers for Disease Control and Prevention (CDC). Antibiotic Resistant Threats in the United States, 2015. Atlanta, Georgia: U.S. Department of Health and Human Services, CDC, 2015.
- CDC. Foodborne Diseases Active Surveillance Network (FoodNet): FoodNet Surveillance Report for 2012 (Final Report) [PDF – 36 pages]. Atlanta, Georgia: U.S. Department of Health and Human Services, CDC. 2014.
- Reactive arthritis after enteric infections in the United States: the problem of definition. Townes JM. Clin Infect Dis. 2010 Jan 15;50(2):247-54.